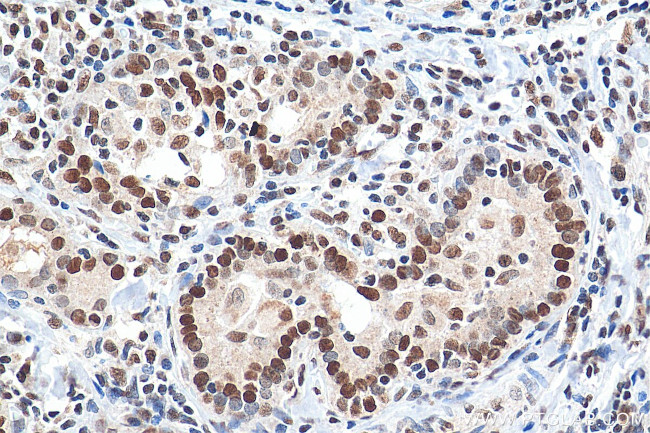
GTF3C2 Antibody in Immunohistochemistry (Paraffin) (IHC (P))

Search
Proteintech
GTF3C2 Polyclonal Antibody
{{$productOrderCtrl.translations['antibody.pdp.commerceCard.promotion.promotions']}}
{{$productOrderCtrl.translations['antibody.pdp.commerceCard.promotion.viewpromo']}}
{{$productOrderCtrl.translations['antibody.pdp.commerceCard.promotion.promocode']}}: {{promo.promoCode}} {{promo.promoTitle}} {{promo.promoDescription}}. {{$productOrderCtrl.translations['antibody.pdp.commerceCard.promotion.learnmore']}}
产品信息
27494-1-AP
种属反应
宿主/亚型
分类
类型
抗原
偶联物
形式
浓度
规格
纯化类型
保存液
内含物
保存条件
运输条件
产品详细信息
Immunogen sequence: GFEDSPDQR RLPPEQESLS RLEQPDLSSE MSKVSKPRAS KPGRKRGGRT RKGPKRPQQP NPPSAPLVPG LLDQSNPLST PMPKKRGRKS KAELLLLKLS KDLDRPESQS PKRPPEDFET PSGERPRRRA A (59-188 aa encoded by BC020981)
靶标信息
Required for RNA polymerase III-mediated transcription. Component of TFIIIC that initiates transcription complex assembly on tRNA and is required for transcription of 5S rRNA and other stable nuclear and cytoplasmic RNAs. May play a direct role in stabilizing interactions of TFIIIC2 with TFIIIC1. [UniProt]
仅用于科研。不用于诊断过程。未经明确授权不得转售。
篇参考文献 (0)
生物信息学
蛋白别名: General transcription factor 3C polypeptide 2; general transcription factor IIIC, polypeptide 2, beta 110kDa; KIAA0011; TF3C-beta; TFIIIC 110 kDa subunit; Transcription factor IIIC 110 kDa subunit; Transcription factor IIIC subunit beta
基因别名: GTF3C2; KIAA0011; TF3C-beta; TFIIIC-BETA; TFIIIC110
UniProt ID: (Human) Q8WUA4
Entrez Gene ID: (Human) 2976